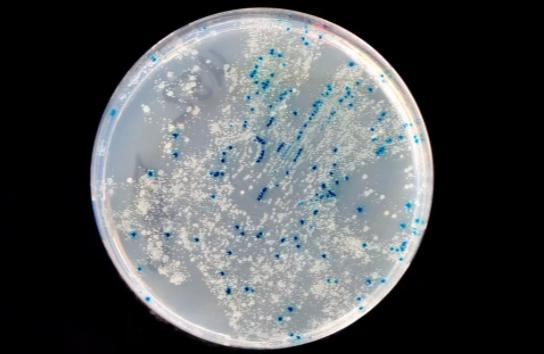
在牛身上掏个洞牛不会痛吗,牛为什么会在身上打洞

来看这头牛,身上被 开了个大口子 ,这是在遭受什么酷刑吗?难道它的主人在虐待它?大家先不要着急,接着往下看。据专家介绍,这个洞有个专业名称,叫做—— 瘘管 ,而被开洞的牛也随之被称为“瘘管牛”或是“空心牛”。

身上有洞的牛
自古以来, 牛 在人们心中简直是 任劳任怨 的典范。它们总是默默地完成人们给它安排的事情,即使这样的任务十分繁重,因此成为了人们从事 农业的好帮手 。同时,牛在畜牧业、乳制品业也充当着重要的角色。而这样默默无闻、无私奉献的牛为何还会被人们在其身上开瘘管呢?人们还经常伸手进去掏,难道牛不会痛吗?
身上有洞的牛
事实上,并 不是所有 的牛都会被开个洞。目前这种情况仅发生在畜牧业发达的国家,譬如美国,而且被开洞的对象也多为 奶牛 。

黑白花纹的奶牛
目前我们常见的瘘管牛的特点是,在其身体表面有一个内径约为 12cm的洞 ,这个洞 直达 牛的瘤胃。洞口则是由一个橡胶(也有塑料、金属材质)套筒覆盖,并配备有一个与之对应的塞子。在需要时,人们可以打开塞子,获取牛瘤胃内的物质,进而判断牛的身体状况并作出相应的对策。

人正在获取牛瘤胃内的物质
但是,别看这只是一个简简单单的洞,里面可还藏着大大的学问。瘘管实质上是一种 医疗手术 ,给牛开瘘管更不只是随随便便开个洞。首先是术前准备。需要被“开洞”的牛不仅在此之前需要进行一系列的体检,还要进行一天的禁食禁水。
其次是 开洞的方法 。需要依靠专业的兽医,从牛的第十三根肋骨下刀,从而直达牛的第一个胃—— 瘤胃 。最后是术后恢复。要随时注意观察术后牛的状态,时刻保持通风,防止蚊虫叮咬产生感染等等。

牛的骨头结构
开洞的原因
既然开洞如此麻烦,那么为什么还要在牛的身上开个洞呢?一方面,是由于牛的 特殊的胃结构 所导致的。
牛拥有 四个胃 ,这四个胃各司其职。但是作为从食道进入后第一个到达的胃,瘤胃却总是不堪负重。据了解,当牛开始进食后,食物首先到达瘤胃,而这里只存在着微生物,它们仅能够对食物进行 初步的分解消化 。

牛身体结构
待需要对食物进行进一步分解消化时,牛便会将之前已经经过初步处理过后的食物 再次送回 到嘴里进行咀嚼, 产生“ 反刍”现象。之后再依次经过牛的其它胃进行处理,最终到达皱胃将食物真正完全地消化干净。
而在这个过程中,瘤胃不仅要充当牛 分解食物的角色 ,还要对牛吃进肚子还未来得及进行消化处理的东西进行保存。随着牛进食数量的增多,瘤胃的 负担 也就随之加重。

牛每天需要吃很多食物
尤其当牛出现反刍障碍时,瘤胃中的食物更是 只进不出 ,从而在其中堆积如山。随后牛便会出现消化不良现象,即分解食物后产生的大量二氧化碳积攒在瘤胃中,使得牛 瘤胃胀气 。这对牛来说十分不利,轻者或许还只是感到胃部不适并不时哞哞叫唤,重者则会使其感到呼吸困难,甚至会因此撑爆瘤胃,进而危及到其生命安全。

人类减缓牛瘤胃部负担
而给 牛开洞 这个方法就为事情带来了转机。通过牛身上的瘘管,人们能够很快地了解到其近来的饮食情况,比如最近牛都吃了些什么。所以一旦瘘管牛出现了异常情况或是患上了疾病,人们就可以直接打开盖子,获取到牛瘤胃中的食物,进而从中寻找答案解决问题。

瘤胃上的盖子
同时,这也在一定程度上解决了牛时常 消化不良 的问题。即使牛吃得过多,无法完全消化,人们也可以通过瘘管将其中多余的食物取出,从而 降低瘤胃的负担 。此外,这也有助于解决牛胃胀气的问题,减少消化不良后产生的废气,从而减少空气中的二氧化碳含量,减缓全球变暖进程。

二氧化碳是全球变暖的罪魁祸首
另一方面,由于其对于 开展研究和治愈其它病牛 有重大意义。从前,科学家们对牛的 消化系统 就十分感兴趣,为了研究其原理,常常需要杀死一头牛或是等牛自然死亡后再进行研究,这使得研究进程十分缓慢并且成本极高。而瘘管的出现,极大地解决了这一问题。

牛的消化系统
科学家们通过给一头牛开瘘管,使其成为 “移动实验室” ,实现一牛多用。当需要进行物质研究时,就通过瘘管直接获取或是将物质投放进去。甚至瘘管牛的瘤胃还可以成为一个小小 优质微生物培养皿 ,利用健康的瘘管牛体内的胃液残渣作为食物喂给病牛,达到 微生物移植 的效果,进而治愈病牛。
微生物培养皿
此外,瘘管在一定程度上还能够提高牛的肉质或奶的产量和质量。通过调整牛的 食物结构 ,从而研究出何种食物能够促进牛产奶或是使牛的肉质更加鲜美。
给牛带来的影响
而这样看似 百利而无一害的瘘管 ,又给牛带来了什么样的影响呢?其实对于牛的日常生活来说,是并没有 太大影响 的,瘘管牛也仅仅只是在外观上比普通牛的身上多了一个东西。但是你可能就会疑惑了,开了个这么大的洞,难道牛不会痛吗?显然 肯定会痛 。试想在日常生活中,倘若我们的手被划了道口子,都会感到疼痛,更何况在牛身上划了这么大一条口子呢。

人类打耳洞都会痛何况牛呢
好在幸运的是,牛的 忍耐力 十分强大,身体的排他性也并不强。并且术前人们会对其进行 局部麻醉 ,术后也会进行一系列的精心照料。同时,瘘管手术现目前也已十分成熟,极少出现手术失败导致牛死亡的现象。

伟大的牛
所以,对于牛来说, 疼痛只是暂时 的,待身体好好恢复后,便可顺利地接受这个 “异物” 的存在。而瘘管牛也正因为瘘管能够及时发现、处理产生的病症的特点,比一般普通牛的免疫力更强,更不易患病,寿命也就随之更长。并且作为实验先驱的它们,为科学、为同类都做出了不小的牺牲和贡献。
反思
但是,对于牛本身来说,瘘管究竟是好是坏,还是值得商榷的。即便瘘管在某种程度上来说,对牛的生存起着 促进作用 ,可牛儿们真正的想法到底是什么我们却不得而知,它们又是否真的愿意被这样在身上开上一个洞?这也就是为什么动物保护协会会认为此种行为属于虐待动物的缘故。

身体完整的牛
并且,从本质上来说,瘘管牛的出现更多地是为了更好地 向人类提供服务 ,无论是提高牛的存活率,促进其产奶,提升其肉质,还是帮助治愈更多的牛,其实都与 人类的需求 息息相关。
我们无法否认,这项技术的 获利者 更大一部分在于我们;也无法否认牛对我们做出的种种贡献与牺牲。切勿因为瘘管对牛产生的部分积极作用而否认了其在另一方面对牛造成的伤害,也切勿产生牛就是为人类而生,我们吃它,研究它都无可厚非的想法。

从古至今一直默默无闻奉献的牛
要知道,同样都是自然界的儿女,并没有高人一等一说,即使弱肉强食,也仍然存在着一定的 自然法则约束 。一旦有人妄图打破这个规则,那么必将受到来自自然界的惩罚。因此,如何与动物们和谐共生,如何与自然和谐相处,实在是我们应该思考的问题。